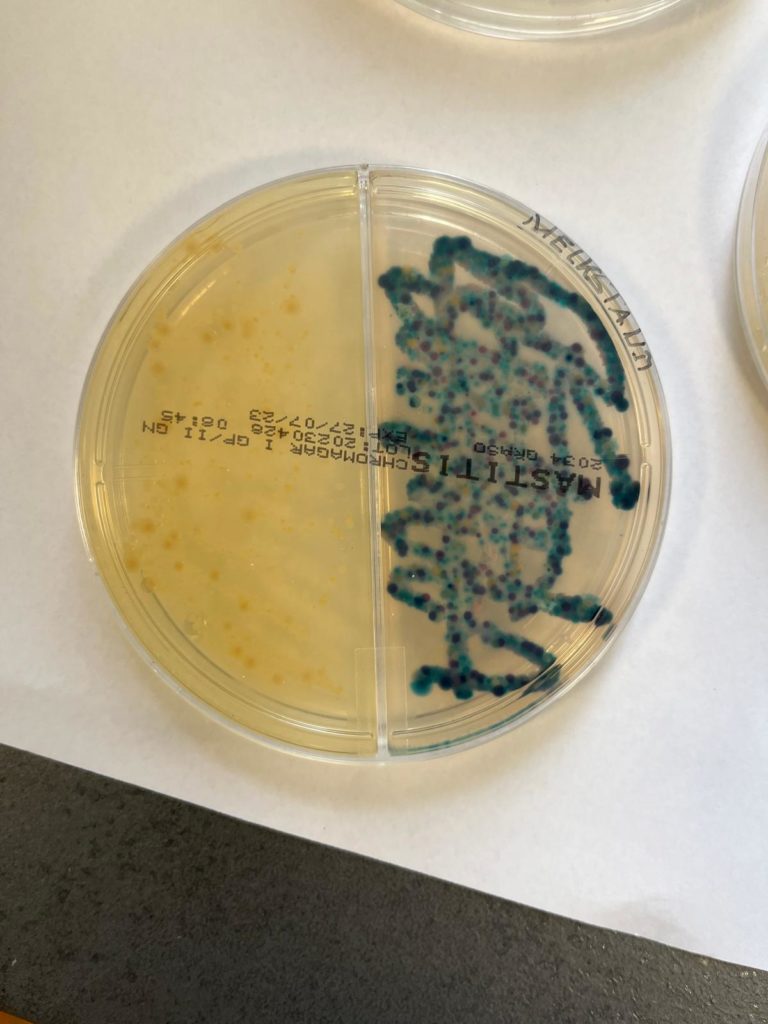
IMG-20240527-WA0021

Großtiere
Leistungen bei Rindern
Wir bieten Beratung und Unterstützung für AMS-Betriebe an.
Klauenbehandlungen und -operationen führen wir regelmäßig oder bei Bedarf auf den Betrieben durch. Dafür steht auch ein praxiseigener Klauenstand zur Verfügung. Weiterhin erfolgt eine Erfassung der Daten durch HERDE Klaue für eine bessere Verfolgbarkeit der Fälle. Wir bieten regelmäßige Klauenpflegetermine im Zwischenintervall des Herdenschnitts durch einen Klauenpfleger an. Bei solchen Terminen können Tiere dem Tierarzt vorgestellt werden, für die das Intervall bis zum nächsten Routineschnitt zu lange dauert.
Wir führen Labmagenoperationen in verschiedenen Varianten (toggeln, endoskopisch – stehend oder mit OP-Wagen –, chirurgisch) durch. Außerdem bieten wir alle weiteren gängigen notwendigen chirurgischen Eingriffe vor Ort im Stall an wie zum Beispiel Kaiserschnitte, rechtseitige Labmagen-OP und Laparotomie, Nabel-OP, Pansenfistel, etc. Dazu gehören auch die Versorgung von Zitzenverletzungen oder Amputationen.
Im Zuge von Einzeltierbehandlungen, aber auch bei Bestandsproblemen führen wir gezielte Untersuchungen durch und erstellen auf den jeweiligen Betrieb angepasste Sanierungskonzepte. Um die Schwachstellen möglichst umfangreich zu sondieren, beziehen wir Technik, Umweltfaktoren, Betriebs- und Melkdaten sowie Probenergebnisse in die Analyse und Beratung mit ein.
Wir bieten umfangreiche Diagnostik im eigenen Labor an. Dort können Milch inkl. Resistenztest, Blut (Festliegen, Leberprofil, Blutbild), Kot (Parasiten) oder Einstreu untersucht werden. Zur weiteren Diagnostik arbeiten wir mit renommierten Fremdlaboren zusammen. Dort lassen wir bei Bedarf auf Grundlage entsprechender Proben (Nasen- Augentupfer, Milchproben, Kotproben, etc.) stallspezifische Impfstoffe herstellen, die genau auf den Betrieb und das jeweilige Problem zugeschnitten sind.
Wir beraten Sie gern hinsichtlich Biestmilchversorgung und untersuchen z.B. IgG-Gehalte im Blut der Kälber als Kontrollpunkt.Wir erstellen auf Grundlage von umfangreicher Diagnostik ( z.B. Kotproben, Augen- und Nasentupfer, Rachenspülproben) individuelle Impf- und Tränkekonzepte und kümmern uns selbstverständlich auch um die Kälber, die akut tierärztliche Unterstützung benötigen.